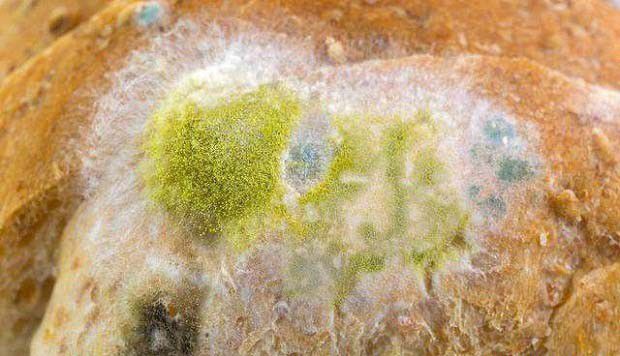
种植灵芝如何防治黄曲霉？

种植灵芝如何防治黄曲霉?
时间:2024-06-17 04:35:07
来源:网络
浏览:3338次
黄曲霉、黑曲霉和灰绿曲霉是侵染灵芝的常见曲霉品种,近期有种植灵芝的网友咨询:黄曲霉对灵芝种植有哪些危害?黄曲霉菌长怎么样,黄曲霉菌适宜的生长条件是怎么样?种植灵芝如何防治黄曲霉,种植灵芝发现有黄曲霉怎么办?以下想种菜网就作简单介绍,供网友们参考。

黄曲霉对灵芝的危害
黄曲霉感染菌木,初时略带黄色,随着菌丝蔓延,菌落变为黄绿色,产生大量的分生孢子,形成二次污染,抢占培养基生长面,造成灵芝菌丝生长缓慢或无法生长,特别是在温度25℃以上时更易产生。

黄曲霉发生规律
黄曲霉分布广泛,存在于土壤、空气及各种F·B的有机体上,分生孢子能借空气传播,在高温、高湿下极易发生。此外,菌袋破口、灭菌不彻底、培养场所通风不良、接种操作带入杂菌等均可造成感染。
灵芝防治黄曲霉措施:
1、培养场地及周边的杂菌污染源要提早清理。
2、培养料彻底灭菌,掌握好灭菌时间,确保培养料温度达到100℃时连续保温10小时。
3、培养菌种期间,要防止出现高温、高湿环境。加强通风换气,降低湿度,防止菌种瓶的棉塞受潮。
4、使用麦粒菌种时,应在冬季接种,不宜在夏天接种,否则易在麦粒上长出黄曲霉。
4、出现黄曲霉侵染后,及时挖出培养料,拌入新鲜培养料中,经灭菌后再利用,也可烧毁或深埋土中。
以上就是想种菜网对灵芝的介绍,如您有更好的补充请在下方留言告诉我们。
